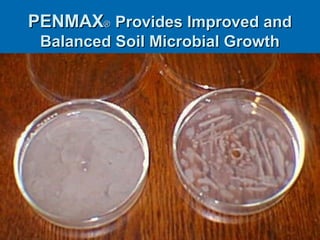
PENMAXPENMAX®® Provides Improved andProvides Improved and
Balanced Soil Microbial GrowthBalanced Soil Microbial Growth

The document compares Penmax® penetrants with other products, highlighting factors such as salt concentration, pH, and soil ecology effects on water penetration. Penmax® improves water retention in soil by over 80%, supports root system expansion, and reduces sodium absorption ratio significantly with an 86% reduction observed. It has been used safely for over 40 years, promoting balanced microbial growth while preventing adverse effects on soil organisms.